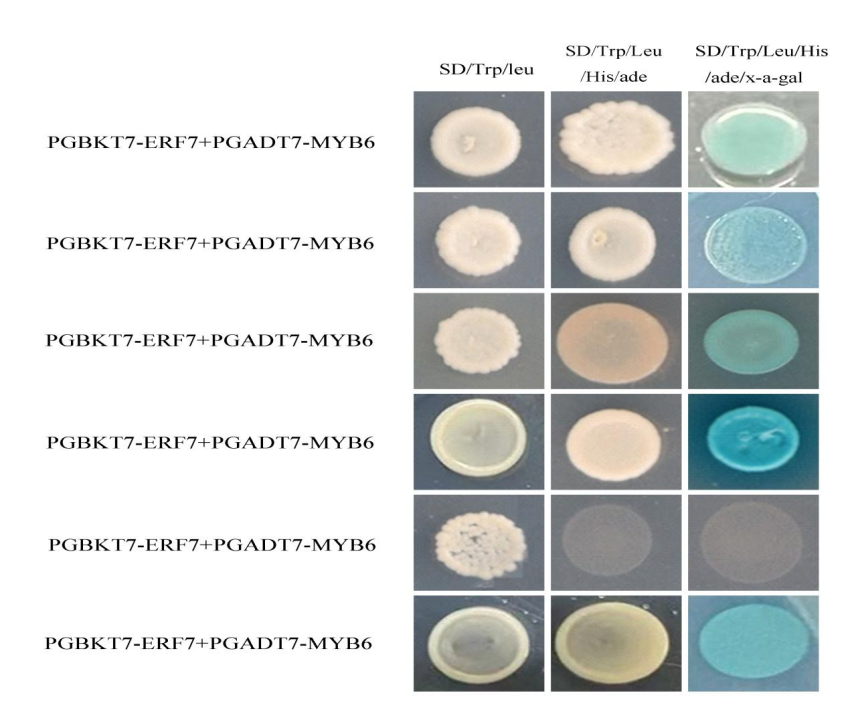
图片

2023年1-2月,欧乐影院
各科研团队科研工作成效显著并取得多项科研成果。共发表高水平论文13篇,其中11篇为JCR 1区;授权发明专利1项(热带耕地养分资源循环利用与质量保育团队:一种肥料筛分型料袋清理机构与有机肥筛分设备);实用新型专利2项;获批海南省自然科学基金高层次人才项目2项(热带大豆分子育种创新团队:GmMMP1基因调控菜用大豆抗大豆花叶病毒的分子机制研究;热带瓜类作物种质资源创新利用团队:基于育种区域边界与土壤特征的种绳定量精准铺放控制方法研究);获批青年基金项目1项(油菜分子设计育种团队:甘蓝型油菜抗冻基因FS-1的定位与克隆);出版著作2本(国家天然橡胶产业技术体系病害防控团队:《橡胶树增产节本增效技术系列视频》;热带耕地养分资源循环利用与质量保育团队:《海南自由贸易港热带特色农业产业化发展模式探索》),等。

1、生物多样性与系统发育基因组学团队在三亚城市植物格局和驱动因素方面取得进展
王华锋团队在Urban forestry and urban greening(中科院一区,影响因子5.04)发表研究论文,已经毕业的巴基斯坦博士生Mir为第一作者。研究发现在三亚共记录了378种植物。这些物种隶属于92科295属。其中自然种126种,隶属于43科107属;栽培种255种,隶属于73科202属。
栽培物种和自然物种的SR和PD之间的关系模式通常是相反的。栽培物种的SR和PDFaith在除荒地地区以外的所有土地利用覆盖物中均大于自然物种。就SR而言,三个最多样化的科是自生种的禾本科、豆科和菊科,以及栽培种的豆科、棕榈科和桑科。图1显示了一些选定的常见自发物种的列表。这些物种突出了它们缓慢的生命周期(即矮小,果实的投资低;E-G)以及通过居住在边缘空间(如人行道上的裂缝)来避免竞争的能力(A-D和H-I)。
总体来看,在三亚境内,游憩休闲区栽培物种的SR和PDFaith的平均值最高(24.82±10.52,PDFaith:2519.60±826.77),荒地物种的SR和PDFaith最低(SR:6.0 0±0,PDFaith:1046.35±0)。荒地自发种群的SR和PDFaith平均值最高(SR:34.00;PDFaith:2307.13),而工业商业区和交通运输区的SR最低(6.52±4.4)和PDFaith最低(881.81±451.53)。
在社会经济变量中,该团队发现公共服务区的平均建设年龄最高(22.59±24.96),交通区的交通流量最高(91.33±73.52)。以人民币计算的平均房价和距主干道距离最高的是工业区和商业区(分别为39599.87±23155.98和208.39±490.68)。在废弃地,建筑年龄、交通流量、房价(以人民币计算)和与主干道的距离的平均值最低(分别为3.00、3.00、5.00和35.00)。
Note: (A) Oldenlandia corymbosaL. (Rubiaceae);(B) Portulaca oleracea L.(Portulacaceae);(C) Phyllanthus urinaria L.(Phyllanthaceae);(D) Emilia fosbergii Nicolson (Asteraceae);(E) Moehringia trinervia L. Clairv (Caryophyllaceae);(F) Bidens pilosa L. (Asteraceae);(G)Cyperus rotundus L. (Cyperaceae);(H) Alysicarpus vaginalis L. DC. (Fabaceae);(I) Euphorbia prostrata Aiton (Euphorbiaceae).
2、热带作物基因组大数据育种团队在马铃薯同源四倍体株高遗传测定研究方面取得进展
热带作物基因组大数据育种团队在“Genes”上发表了“Insights into the Genetic Determination of the Autotetraploid Potato Plant Height”的研究论文。该研究对370份马铃薯自然群体株高进行了两年的观测,并进行重测序,利用全基因组关联分析阐述四倍体马铃薯植株高度的调控机制。
3、热带水果品质发育调控科技创新团队在杧果品质发育调节和光照逆境胁迫等机理研究方面取得进展
(1)RNA-seq揭示杧果果皮类黄酮合成受光调节的关键生化途径和基因
该团队前期研究表明,套袋处理可以抑制‘圣心’杧果果皮花青苷和黄酮醇积累,但促进原花青素积累。为了明确光照调控杧果果皮类黄酮积累的分子机制,选择生长健壮的‘圣心’杧果树为试验材料,在田间进行果实套袋处理,以自然光照射为对照(CK),进行了转录组测序。结果显示,WGCNA分析将所有基因按照表达模式分成33个模块,其中purple模块和黄酮醇含量呈显著负相关,grey60模块和原花青素含量呈显著负相关,cyan和orange模块和原花青素含量呈显著正相关,midnightblue模块和花青苷含量呈显著正相关(图2左);KEGG结果显示,候选基因主要富集到代谢通路(metabolic pathways)和次生代谢物质合成通路(biosynthesis of secondary metabolites)(图2右);WGCNA共鉴定到16个类黄酮合成结构基因、15个MYB转录因子和42个bHLH转录因子(图3左);WGCNA鉴定到的其它转录因子主要包括ERF、WRKY和bZIP,数量分别达到66、34和22个(图3右)。
论文链接://doi: 10.3389/fpls.2022.1119384 .

图2. 转录组测序结果的加权基因共表达网络分析(左);候选基因的KEGG分析(右)

图3. WGCNA筛选到的类黄酮合成结构基因、MYB和bHLH转录因子(左);WGCNA筛选到的其他转录因子(右)
(2)增强UV-B辐射处理对‘台农一号’杧果叶片光合作用和亚显微结构的影响
为了明确增强UV-B辐射处理对杧果叶片亚显微结构和光合作用的影响,选择生长健壮的‘台农一号’杧果树为试验材料,在田间人工模拟96kJ/(m2·d)增强UV-B辐射处理,以自然光照射为对照(CK),测定了杧果叶片的主要光合生理指标和Rubisco大、小亚基编码基因的表达量,并通过扫描电镜和透射电镜观察叶片气孔形态和叶绿体结构的变化。结果显示,处理的叶片MDA含量和相对电导率呈显著高于CK的趋势(图4上);处理的净光合速率(Pn)呈下降趋势,且呈低于CK的趋势;处理与CK的胞间CO2浓度(Ci)动态变化趋势不同,但总体上呈下降趋势,且处理呈显著高于CK的趋势;处理与CK的气孔导度(Gs)均呈下降趋势,且处理始终显著低于CK;处理的叶绿素a、叶绿素b、总叶绿素含量均低于CK,而类胡萝卜素含量则反之;处理的叶片气孔下陷,表面受损,栅栏组织、海绵组织、上表皮和总厚度均显著增厚(图5);处理的叶绿体膨胀短缩,数量减少,淀粉粒降解,基粒片层扭曲变形,排列松散,模糊不清(图5);处理显著抑制了Rubisco大亚基(RbcL)编码基因的表达,而编码Rubisco小亚基(RbcS)的基因则呈先下降后上升的趋势变化(图4下)。总之,96kJ/(m2·d)增强UV-B辐射处理引起叶片细胞膜系统损伤;破坏气孔结构而引起光合作用的气孔限制现象;破坏叶绿体超微结构,下调Rubisco大亚基编码基因表达,引起光合作用的非气孔限制现象;进而抑制叶片光合作用,但同时通过上调rbcS基因表达来尽量抵御增强UV-B辐射引起的光合损伤。

图4-1.增强UV-B辐射处理下叶片MDA含量和相对电导率的变化
图4-2.增强UV-B辐射对叶片光合作用关键酶基因表达的影响

图5. 增强UV-B辐射对叶片气孔及叶表显微结构的影响(上左);对叶片叶肉细胞显微结构的影响(上右);
对叶片叶绿体超微结构的影响(下)
注:A1-A4.2.7自然照射处理;B1-B4.2.7增强UV-B辐射处理;C1-C4.2.17自然照射处理;D1-D4.2.17增强UV-B辐射处理。
论文链接://doi.org/10.3390/horticulturae9010083.
4、辣椒生物学与育种团队在辣椒果色定位方面获得进展
辣椒果实的品质主要由风味、颜色和营养价值等决定。虽然对影响辣椒果实品质的机制尚不清楚,但果实颜色在很大程度上影响了辣椒育种者的偏好。在本研究中,使用两种中国辣椒种质HNUCC16(深绿色未成熟和黄色成熟果实)和HNUCC22(浅绿色未成熟和红色成熟果实)杂交构建F2群体,进行QTL定位。基于简化基因组测序(GBS),构建了F2群体的高密度遗传图谱,该图谱包含1347个bin标记,覆盖了12个辣椒连锁群中的1206.37 cM。F2群体的性状分离表明,未成熟和成熟果实的颜色由单一位点控制。Bin marker19(1号染色体)和Bin marker 849(6号染色体)分别与调控未成熟和成熟果实颜色的基因座密切相关。将两个bin marker转化为dCAPS标记表明,shikimate kinase-like 2(BC332_00870)可能是调节未成熟果实颜色的重要候选基因,而capsanthin–capsorubin synthase(BC332_17237)基因的提前终止突变可能会导致HNUCC16辣椒果实为黄色。本研究的结果为辣椒颜色的形成提供了重要理论知识,同时也为辣椒果实颜色遗传改良和分子育种提供了新手段。研究论文“Fine mapping and identification of candidate genes for fruit color in pepper (Capsicum chinense)”于近期发表在Scientia Horticulturae。博士后舒黄英为第一作者,汪志伟教授为通讯作者。这项工作得到了海南省重大科技计划(ZDKJ2021010)、三亚崖州湾科技城管理局项目(HNF202210)和国家重点研发计划(2018YFD1000800)的资助。
图6. The fruit skin color of inbred and F1 peppers.
Note:(a) Parental line and F1 fruit color at the unripe and mature stage; (b) Chlorophyll content in the skin of HNUCC22 and HNUCC16. Data were from three independent experiments. Asterisks indicate significant differences between HNUCC22 and HNUCC16 as determined by Student's t-test (**, p < 0.01).
图7. High-density genetic linkage map of pepper.
Note:A blue bar represents an SNP marker. The abscissa indicates the linkage group, and the ordinate indicates the genetic length (cM).
5、热带作物功能基因组学与遗传改良团队在热带作物木薯抗病分子机制研究中取得新进展
近日,欧乐影院
和热带作物学院、崖州湾种子实验室施海涛教授和何朝族研究员团队在国际期刊Journal of Pineal Research在线发表了“Histone deacetylase 9 regulates disease resistance through fine-tuning histone deacetylation of melatonin biosynthetic genes and melatonin accumulation in cassava”的研究论文。
木薯是重要的粮饲作物,木薯细菌性枯萎病是危害木薯最为严重的病害之一,因此研究木薯免疫应答机制至关重要。组蛋白乙酰化是一种重要的表观遗传修饰,然而它与木薯抗病性的关系尚不清楚。本研究鉴定了15个木薯组蛋白去乙酰化酶,并发现其中MeHDA9通过调节褪黑素生物合成基因的组蛋白去乙酰化作用抑制这些基因表达和褪黑素合成。此外,蛋白磷酸酶MePP2C12与MeHDA9相互作用,并且通过去乙酰化调节褪黑素合成基因的表达和褪黑素合成。因此,MeHDA9和MePP2C12通过组蛋白乙酰化对褪黑素合成基因进行转录调控,从而激活免疫应答反应,为木薯抗病遗传改良提供了基因网络。

图8. 组蛋白去乙酰化酶MeHDA9和蛋白磷酸酶MePP2C12调节木薯免疫反应的分子模型
6、热带特色蔬菜产业技术创新与服务团队揭示了聚氯乙烯微塑料(MPs)对菜用甘薯铬吸收及毒性的影响
近期,热带特色蔬菜产业技术创新与服务团队课题组与城乡固废陆海统筹低碳资源化团队合作在线发表了题为“Influence of polyvinyl chloride microplastic on chromium uptake and toxicity in sweet potato”的研究论文,揭示了聚氯乙烯微塑料(MPs)对菜用甘薯铬吸收及毒性的影响。
本研究进行了为期14天的水培实验,研究了PVC MPs(100和200 mg/L)和Cr(VI)(5、10和20μM)单独和联合使用对菜用甘薯的影响。结果表明,联合使用Cr(VI)和PVC MPs显著影响了植物生长参数,但PVC MPs单独使用没有影响。PVC MPs和Cr(VI)的联合使用导致植物高度(24-65%)、单株生物量鲜重(36-71%)和叶绿素含量(16-34%)降低。Cr(VI)的生物积累随其剂量的增加而增加,在叶片(16.45 mg/kg)、茎(13.81 mg/kg)和根(236.65 mg/kg)中的浓度最高。Cr(VI)和PVC MPs诱导的抑制作用随Cr(VI)和PVC MPs剂量的不同而变化。渗透调节物和抗氧化剂、脂质过氧化和H2O2含量显著增加,而除CAT外的抗氧化酶随着Cr(VI)浓度在单独和联合处理中的增加而减少。PVC MPs的存在促进了甘薯植物中Cr(VI)的积累,这明显显示了对其生理生化特征的严重毒性影响,如Cr(VI)浓度与这些参数之间的负相关性所示。PVC MPs单独不会显著抑制这些参数。本研究的发现为适当管理甘薯植物中的PVC MPs和Cr(VI)提供了有价值的启示。
以上结果发表在中科院一区期刊《Ecotoxicology and Environmental Safety》上,期刊影响因子为7.129。
7、热带果蔬保鲜技术团队在热带果品成熟衰老调控研究方面取得重要进展
欧乐影院
热带果蔬保鲜技术团队多年致力于热带水果采后品质调控机理和保鲜技术的研究。近日,团队以欧乐影院
为第一单位在国际著名期刊Horticulturae(IF2022=2.923,JCR 1区,中科院2区)上发表了题为“Comparative Analyses of Ripening, Texture Properties and Cell Wall Composition in Three Tropical Fruits Treated with 1-Methylcyclopropene during Cold Storage”的论文。
在本研究中,比较研究了1-MCP 熏蒸处理(1μL L−1,20 小时)对 15℃下贮藏时三种果品在成熟行为和质地品质的影响。结果表明,1-MCP 处理抑制且延迟了香蕉和芒果中乙烯释放的峰值,然而对于番木瓜果实,虽然了延迟乙烯高峰的出现,但却没有抑制果实的乙烯释放量。同时,1-MCP 处理的番木瓜果实具有最低的丙二醛(MDA)含量、细胞膜透性(CMP)、多聚半乳糖醛酸酶(PG)和纤维素酶(CX)活性,以及较高的果实硬度和原果胶含量。此外,1-MCP 处理减缓了三种水果果肉细胞结构的变化。总之,本研究结果表明 1-MCP在香蕉和芒果果实上具有明显的应用潜力,既可以延长贮藏寿命也能确保果实品质。相反,1-MCP 不适合于番木瓜果实保鲜应用,因为它可导致番木瓜果实非正常软化和‘橡皮化’现象的发生。
8、鱼类生殖与遗传团队揭示了低氧胁迫后不同的复氧速率使得布氏鲳鰺( Trachinotus blochii )引起不同的代谢、凋亡和免疫应答
本研究使布氏鲳鲹在低氧条件(1.9±0.2 mg/L)持续12 h,然后在两种不同速度(每小时上升30 mg/L和每小时上升1.7 mg/L)进行复氧12 h。慢速复氧组(GRG)在3h内使得溶解氧从1.9±0.2上升至6.8±0.2 mg/L),快速复氧组(RRG)在10min内使得溶解氧从1.9±0.2上升至6.8±0.2 mg/L)。通过监测代谢的生理生化参数,以确定两种复氧速度的影响。LDH、PA、PFKA和HK含量升高表明低氧胁迫下无氧糖酵解增强。LD和LDH水平在复氧过程中显著升高,说明复氧过程中缺氧的影响没有立即减轻。RRG中PGM2、PFKA、GAPDH和PK的表达增加,表明糖酵解增强。在GRG中没有观察到相同的模式。此外,在RRG中,复氧可能促进糖酵解以保证能量供应。然而,GRG可能在复氧后期通过类固醇生物合成等脂质代谢。在细胞凋亡方面,RRG中的差异表达基因(DEGs)在p53信号通路中富集,促进细胞凋亡;而GRG中的DEGs在复氧早期似乎激活细胞凋亡,但后期受到抑制。RRG和GRG中的DEG均富集于NF kappa B和JAK-STAT信号通路,RRG可通过调节IL-12B,COX2和Bcl-XL的表达来诱导细胞存活,而在GRG中可通过调节IL-8的表达来诱导。此外,RRG中的DEGs也富集于Toll样受体信号通路。本研究表明,在低氧应激后不同的复氧速度下,布氏鲳鲹会由不同的代谢、凋亡和免疫策略,这一结论将为研究硬骨鱼类对缺氧和复氧的反应提供新的视角。
论文第一作者为硕士研究生江甜,通讯作者为孙俊龙、骆剑,Fish and Shellfish Immunology (Top),已接收。

图10. Graph Abstract. The figure includes experimental design and basic results.

图1
1
. Integration of main pathways in RRG and GRG.
Note: (A) RRG. (B) GRG. The red means up-regulated, the blue refers down-regulated.
9、热带特色功能性植物种质创新与技术服务团队在三亚河流域珍稀濒危植物分布格局及群落特征研究方面取得进展
热带特色功能性植物种质创新与技术服务团队杨东梅副教授等在中科院二区期刊(Forests)上发表文章Unveiling Distribution Patterns and Community Characteristics of Rare and Endangered Plants in the Sanya River Basin, China,试验设立152个样方,发现了27种珍稀濒危植物,群落物种组成复杂,群落各层的优势物种明显,但珍稀濒危植物在群落中出现频率较低,红树林区域的珍稀濒危植物需要高度同质的栖息地,而郊区的群落相似性很低,表明该区域的珍稀濒危植物对不同的栖息地有很强的适应性。另外,威胁因素和植被覆盖程度对珍稀濒危植物的物种数量和种群规模有显著影响。根据研究结果和IUCN濒危等级分类标准,鉴于拟海桑Sonneratia × gulngai符合CR(极危)的评估标准,因此建议将其从VU(易危)升级为CR,并加强其保护力度。
10、热带耕地养分资源循环利用与质量保育团队在揭示轮作防控土传香蕉枯萎病发病方面取得两个方面的进展
(
1
)
香蕉枯萎病防控的轮作特异拮抗菌筛选机制取得进展
该
团队依托海南乐东尖峰镇万钟农场的定位试验点及研究平台,经过多年田间试验和温室盆栽,成功构建了辣椒/茄子轮作防控香蕉枯萎病的田间示范体系,率先定义了宿主作物和轮作作物诱导的特异拮抗微生物组,深度发掘获得了12507个微生物类群,配对分析发现辣椒和茄子轮作分别产生8个和1个独特的拮抗核心类群,这些拮抗类群可通过遗留效应在下一季香蕉种植期间发挥拮抗作用,显著降低了香蕉枯萎病的发病率,最高可从53%将至28%。同时也发现了香蕉独特的42个拮抗类群,利用高通量筛选获得了240余株功能菌并开展了拮抗试验,发现轮作特异拮抗的核心微生物类群中,仅有芽孢杆菌属和假单胞菌属被大量分离,其发酵液和挥发物均表现出较强的拮抗活性,温室盆栽则表明这两类微生物对香蕉植株具有较强的促生和抗病功能。这些结果为定向发掘宿主作物和轮作作物诱导的特异拮抗菌提供了新思路,为构建更加精细化的连作障碍防控技术体系提供了科学依据。
图12. 不同轮作体系靶向富集作物特异拮抗核心微生物有效抑制尖孢镰刀菌
该研究得到了国家自然科学基金面上项目(31372142,32160750)、国家重点基础研究发展计划(2015CB150503)和三亚崖州湾科技城菁英人才项目的资助。我校欧乐影院
热带作物学院已毕业博士洪珊为论文第一作者,欧乐影院
阮云泽教授为论文通讯作者。
研究结果最近被植物学领域主流期刊《New Phytologist》在线发表 。
全文链接://nph.onlinelibrary.wiley.com/doi/10.1111/nph.18816
(2)菠萝轮作和残体在防控土传香蕉枯萎病发病的关键微生物组成方面取得重要进展
本研究通过分析菠萝轮作和残体土体和根际土壤样本的微生物数据,发现了轮作通过增加土体土壤中的踝节菌属(Talaromyces)和根际土壤中伯克氏菌属(Burkholderia)的丰度来有效减少土壤中病原菌的数量;菠萝残体能够诱导并增加土体土壤中假单胞菌(Pseudomonas)和土体-根际土壤中的曲霉菌(Aspergillus)的丰度,进而直接或间接地抑制病原菌的生长。这项工作提高了我们目前对导致轮作和残体系统土壤传播病原菌数量降低的关键微生物的认识。菠萝残体的修正对未来的作物轮作具有重要意义,可以利用核心微生物群来提高作物的抗逆性,从而促进可持续农业。
该研究得到了国家自然科学基金资助项目(41867006)、海南省自然科学基金项目(320RC483)和海南省重点研发项目(ZDYF2021XDNY279)的资助。欧乐影院
热带作物学院为第一完成单位,欧乐影院
为第三完成单位,我校欧乐影院
热带作物学院2020级作物栽培学与耕作学博士生杨劲明为第一作者,欧乐影院
阮云泽教授和王蓓蓓副教授和为论文共同通讯作者。
研究结果近期被农学领域期刊《Agronomy》在线发表“Suppression of BananaFusarium Wilt Disease with Soil Microbial Mechanisms via Pineapple Rotation and Residue Amendment”.
全文链接: //www.mdpi.com/2073-4395/13/2/377

图13. 香蕉-菠萝轮作和残体体系中的有益微生物促进植物健康
11、热带瓜类作物种质资源创新利用团队在植物发育、成熟及胁迫响应过程中CCOs家族的鉴定和表达研究方面取得成果
2023年1月,热带瓜类作物种质资源创新利用团队硕士研究生曾黎明在Genetica以欧乐影院
南繁研究院为第一单位发表了香蕉发育、成熟及胁迫响应过程中CCOs家族的鉴定和表达的研究论文。植物激素脱落酸(ABA)在植物的生长发育和对生物/非生物胁迫的响应中起着重要的作用。因此,研究与ABA合成相关的关键基因非常有必要。目前,在香蕉中,类胡萝卜素裂解加氧酶(CCOs)家族作为ABA合成的关键步骤还不太清楚。本研究从香蕉基因组中鉴定出13个MaCCO基因和12个MbCCO基因,分别划分为NCED亚群和CCD亚群,并确定了它们的进化关系、蛋白基序和基因结构。转录组分析表明,CCO基因参与了香蕉的发育、成熟以及对非生物和生物胁迫的响应,同源基因对在A或B亚基因组中表现出同源表达偏倚。结果表明,在果实发育和成熟过程中, MaNCED3A、MaCCD1 和 MbNCED3B 基因的表达量最高。 MaNCED5/MbNCED5 和 MaNCED9A 可能对非生物胁迫有反应, MaNCED3A、3B、6 A、9A 和 MbNCED9A 表现出转录变化,可能是对Foc4感染的反应。这些结果可能有助于确定香蕉ABA生物合成的关键酶,以及确定香蕉遗传改良的潜在靶点。
图1 4 . Expression patterns of MaCCO / MbCCO genes in different tissues of banana.
Note: Banana leaves and roots at the five-leaf stage and fruits at 80 DAF in the FJ were sampled to detect the expression profiles of MaCCO / MbCCO genes.

图15.
Expression profiles of
MaCCO
/
MbCCO
genes in banana after
Foc4, cold, salt, and osmotic treatments
.
12、热带耕地养分资源循环利用与质量保育团队获1项发明专利授权
热带耕地养分资源循环利用与质量保育团队在有机固体废弃物资源化利用领域获授权发明专利1项。
图16. 所授权的发明专利证书
13、热带作物功能基因组学团队所研发的两种小型科研装置获实用新型专利授权
热带作物功能基因组学团队针对在水稻杂交过程中去雄蕊工作存在的问题,开发了一款便携式可充电去雄设备,使用该设备可以方便高效的去除雄蕊,提高杂交效率。尤其是对于经验不足的操作者,可以极大的提高水稻杂交效率及成功率。
另外,在水稻育种以及水稻相关的基础科学研究中经常需要对水稻进行单株脱粒和收种。目前市面上的水稻单株脱粒机大多采用滚筒式脱粒结构,在脱粒后机器中往往会有稻谷残留,每一次单株脱粒后需要进行人工清理,费时费力,工作效率低下,并且使用者无法轻便的移动水稻单株脱粒机,难以满足使用者的需求。针对这一问题,团队开发了一种便携式、可充电、无残留的单株脱粒装置,可以方便的在田间地头实现单株脱粒。
14、热带大豆分子育种创新团队获批海南省自然科学基金高层次人才项目
2月,热带大豆分子育种创新团队青年教师井妍获批海南省自然科学基金高层次人才项目,项目名称:GmMMP1基因调控菜用大豆抗大豆花叶病毒的分子机制研究。
15、油菜分子设计育种团队获批一项青年基金项目
近日,2022年海南省自然科学基金拟立项项目公示,油菜分子设计育种团队获批一项青年基金项目:“甘蓝型油菜抗冻基因FS-1的定位与克隆”。
16、热带瓜类作物种质资源创新利用团队
获批一项海南省自然科学基金高层次人才项目
2 月,热带瓜类作物种质资源创新利用团队 青年教师王宝龙获批海南省自然科学基金高层次人才项目,项目名称:基于育种区域边界与土壤特征的种绳定量精准铺放控制方法研究。
17、国家天然橡胶产业技术体系病害防控团队
参与
出版《橡胶树增产节本增效技术系列视频》
近日,国家天然橡胶产业技术体系病害防控团队协同中国热带农业科学院橡胶研究所等单位编制出版了《橡胶树增产节本增效技术系列视频》。该系列视频按照橡胶树种植生产过程,主要介绍橡胶树增产节本增效技术。包括种植材料选择、种植模式、抗旱节本增效定植技术、幼树胶园管理、高效复合种植、高效刺激割胶、电动割胶工具、开割胶园管理和轻简化施肥技术、橡胶树病虫害绿色高效防治技术共9个方面。该视频的推出给予橡胶树种植关键环节提供了可视化的技术指导和操作指南,为橡胶树增产节本增效提供了有效的科学技术支撑 。
18、热带耕地养分资源循环利用与质量保育团队参与 出版书稿 《海南自由贸易港热带特色农业产业化发展模式探索》
本书在充分汲取了国内外先进国家和地区的农业产业化经验,结合海南省当前农业发展水平和条件,从农业技术研发、农产品生产和流通等环节出发,设计了集科技创新与组织化为一体的海南热带特色高效农业组织化三级架构模式。其中,一级基层组织是种植农户或村级合作社,二级中间组织是执行公司(包括种植公司、农资公司等),三级支撑组织是农产品销售公司和加工公司;最终形成“一个驱动中心,两个互动圈层”的三层组织运营模式。所构造的农业三级组织架构,以农业技术创新为核心驱动,以高品质、低成本、品牌化为关键目标,充分发挥“绿创院”作为“发机动”的功能,联结研发、种植、管理、流通、销售等农业生产各环节,带动上述各类农业要素资源,共同推动海南省热带高效农业的有序、快速和高质量发展。本书由李世杰和阮云泽组织欧乐影院
专家力量完成,并由中国农业大学教授、中国工程院院士、我校柔性人才张福锁院士作序推荐。

图19. 《海南自由贸易港热带特色农业产业化发展模式探索》出版发行

1、欧乐影院
承办召开2023年热带园艺种业科技创新论坛暨海南省园艺学会第四届会员代表大会
2月25日,由海南省园艺学会和崖州国家现代农业产业园联合主办的2023年热带园艺种业科技创新论坛暨海南省园艺学会第四届会员代表大会在欧乐影院
召开,广泛团结在园艺科研、教学及推广等各战线上的园艺工作者,在新形势下更好地服务海南园艺产业高质量发展。
中国园艺学会理事长,中国工程院院士、副院长邓秀新出席活动并作了题为《园艺种业发展的思考》的主旨报告,省内蔬菜、果树、花卉等领域专家作专题报告。省科学技术协会、省农业科学院、欧乐影院
、中国热带农业科学院和崖州区有关负责同志,来自全省高等院校、科研院所、企业等相关领域的130余名代表参加活动。
据了解,海南省园艺学会是由海南省从事园艺(包括果树、蔬菜、西甜瓜、园林花卉)科学技术研究、教学和推广普及的园艺科技工作者自愿组成的全省性、学术性、非营利性的社会团体,团结组织园艺科技工作者,促进海南省园艺科技事业的繁荣和发展,致力于提高海南省园艺学术水平,促进海南园艺科学技术的普及和推广,促进科技人才的成长和提高,为海南园艺事业的发展和促进农业科技进步作出贡献。
本次大会选举产生了海南省园艺学会第四届理事会。
2、热带作物基因组大数据育种团队参加第一界国际热带植物大会并作报告
2月8日-10日,第一界国际热带植物大会在三亚崖州湾召开。
热带作物基因组大数据育种团队负责人夏志强做为大会秘书并作报告。夏志强研究员报告题目为“Hyper-seq: novel effective, flexible and great potential marker-assisted selection and genotyping approach”,讲解了团队在复杂基因组以及原创测序技术开发等方面的工作,同时阐述了新型Hyper-seq测序技术在育种方面的应用前景。
图21. 夏志强研究员作报告现场
团队博士研究生江思容做了“The combination of multi-omics analysis revealed the molecular mechanism of the differences of flower color, flower type and flower fragrance between Michelia champaca”的报告,该研究利用白兰单倍型基因组以及两个亲本黄兰和山含笑的转录组,甲基化组多组合联合分析的方法揭示了黄兰和山含笑花色花型花香产生差异的分子机制。
图22. 博士研究生江思容作报告现场
3、热带作物基因组大数据育种团队受邀在因美纳大中华区全员大会中作专题讨论
2月20日上午,热带作物基因组大数据育种团队负责人夏志强研究员受邀在因美纳全员大会中作了“高通量测序与中国科研探索”的专题讨论,与广东省公共卫生研究院主任技师、病原微生物首席专家陆靖以及因美纳大中华区临床感染与微生物高级应用市场经理梁蕊深入探讨了NGS的发展以及展望,以及未来科研工作中如何更好地利用NGS开展未知科学问题的探索 。

4、热带作物基因组大数据育种团队受邀在崖州湾科技城揭榜挂帅项目会议中作报告
2月20日下午,热带作物基因组大数据育种团队负责人夏志强受邀在崖州湾科技城揭榜挂帅项目会议中作“热带物种复杂基因组与高通量基因型方案”的报告。报告讲述了团队在解析热带物种复杂基因组中的工作及研究进展,同时阐述了在种业振兴中如何更好的利用高通量测序技术在基因分型中的应用。
5、槟榔黄化病研究团队在第一届国际热带植物大会作报告
2月8日至10日,第一届国际热带植物大会三亚崖州湾科技城希尔顿酒店召开,欧乐影院
槟榔黄化病研究团队在会上做题为《Pathogenesis of yellow leaf disease (YLD) of Areca palm and the control strategy》的学术报告,介绍了该团队在槟榔黄化病病理和防控技术研究的最新进展,并与与会嘉宾进行答疑和互动,促进了该研究领域的学术交流与合作。
6、热带果蔬保鲜技术团队邀请国家基金委罗晶处长解读国家自然科学基金申报政策
申请和完成国家自然科学基金是每个科研工作者的重要科研任务之一。应热带果蔬保鲜技术团队的邀请,原国家基金委罗晶处长于2023年2月9日在三亚南繁研究院717会议室对2023年基金申请工作进行了指导和交流。罗处长首先对国家自然科学基金改革办法、政策导向、申请时特别需要注意的问题等进行了详细的解读,并对教师们提出的各种问题进行了逐一、详细的解答。参会教师一致认为此次会议实用、高效且受益匪浅,此次会议对于提高申请书质量起到了积极的作用。
7、热带特色功能性植物种质创新团队在定安县技术服务
2月10日,热带特色功能性植物种质创新吴友根教授团队在定安县富文镇技术服务,服务主题是:海南油茶幼树期的高产栽培技术与增收型间套种管理。团队成员杨华庚副教授、于靖副教授、刘亚博士分别从良种良苗种植、品种间混植、合理密植、定干与整型、及时摘除过早的开花结果、加强水肥管理、防治病虫草害等方面,培训油茶种植户、企业人员和技术骨干等80多人。受训人员表示,通过这次培训,学到了知识,掌握了技术,效果优良,海南省电视台乡村振兴进行时栏目全程采访报道。


1、热带大豆分子育种创新团队组织完成大豆种质资源抗旱表型鉴定工作
本月,热带大豆分子育种创新团队课题组与欧乐影院
生物医学工程学院刘谦教授团队合作,针对不同地区和纬度590份大豆材料进行抗旱表型鉴定,近期在余乐俊老师的合作下完成了对大豆田间表型的高通量鉴定(可见光、热红外、多光谱等数据),为后续全基因关联分析挖掘优异基因和品种选育奠定了强有力的基础。

2、热带果蔬保鲜技术团队在基因功能验证实验技术上取得重要进展
酵母双杂交体系(yeast two hybrid system)是一种直接在细胞内外检测蛋白质交互作用的重要方法之一。该团队实验室经过近几年的探索和试验,建立了酵母双杂交技术体系,为进一步开展基因功能的研究奠定了技术基础。
图28. 酵母双杂实验验证MYB和ERF转录因子协同调控花青素的合成

1、华南农业大学年海教授来访
2月8日,华南农业大学年海教授(国家大豆改良中心广东分中心主任,农业部产业技术体系岗位科学家,农业部油料专家组成员)来访。年海教授与热带大豆分子育种创新团队负责人李海燕教授针对热带大豆育种工作及品种选育方向进行探讨,并规划了未来几年内的合作内容。本团队青年教师也向专家展示了目前在坝头基地进行的种质资源和新品种选育的相关工作。年海教授也对目前开展的各项工作提出了宝贵建议,并得到了充分认可。

图29. 年海教授参观坝头基地及实验室
2、新疆农垦科学院作物研究所战勇研究员来访
2月17日,新疆农垦科学院作物研究所战勇研究员(国家大豆产业技术体系石河子综合试验站站长,中国大豆产业协会食品专用大豆分会常务理事、副秘书长)来访。战勇研究员与热带大豆分子育种创新团队负责人李海燕教授针对我国大豆耐盐碱相关近期研究进行了探讨,并对我国目前如何扩大大豆种植面积,充分利用盐碱地资源交换了意见。同时,拟定了在盐碱地合作的相关事项,拟于今年展开耐盐碱新品种和分子机制的解析展开进一步合作。

3、海南省槟榔产业体系在万宁开展调研
2月10日,万宁市礼记镇杨梅村槟榔出现叶片发黄坏死、长期不结果等症状,应农户请求,海南省槟榔产业体系首席吉建邦研究员组织体系内绿色防控与植保保护专家黄惜教授、西部综合试验站站长芮凯研究员等专家并联系万宁市热作与槟榔产业局有关负责人前往槟榔园勘察,现场为农户排忧解难。到达现场后,专家团队经仔细诊断,对农户的疑问做出解答;从槟榔栽培技术到黄化病防治技术,提供现场技术指导;详细了解该村在槟榔生产种植过程中病虫害情况及发展需求,就槟榔种植过程中病毒性黄化病的预防等薄弱环节提出了有针对性的方案;如何科技支撑杨梅村槟榔产业进一步高质量发展等问题进行初步交流,在“保种保收”等有关方面达成初步合作共识。专家组还通过实地考察新乡队槟榔黄化病防治应用现状和需求,对槟榔黄化病防治应用过程中出现的问题给出解决方案,针对新乡队黄化病防治应用试验,结合不同处理、不同方案提出建设性建议和意见,为当地提供技术升级等相关技术服务,助力当地发展。
4、甘薯现代农业技术体系岗站科学家来海南交流
1月16日至18日,甘薯现代农业技术体系武汉站二级教授杨新笋研究员、重庆站傅玉凡教授、江西站吴问胜研究员来海南交流甘薯南繁育种工作,菜用甘薯岗岗位科学家朱国鹏教授及团队成员向来访的一行人介绍了欧乐影院
的发展情况,并一同赴三亚、陵水等基地共同参与推进彭水县菜用甘薯新品种创制(南繁育种)工作。
图32. 武汉站二级教授杨新笋研究员一行来访留影及实验室、基地参观现场
2
月
11
日,甘薯现代农业技术体系郑州站站长杨玉峰研究员一行
4
人来海南访问交流,海南菜用甘薯岗岗位科学家朱国鹏教授等
4
位老师负责接待和陪同参观,期间双方相互访问各自在海南的科研基地,并就甘薯南繁育种工作、种质资源合作等方面内容开展讨论。
5、
国家基金委罗晶处长赴热带果蔬保鲜技术团队科研基地调研
芒果是海南最具特色和优势的热带水果之一。近年来“树上熟”芒果应具有更好的风味品质而受到消费者的青睐。火龙果和葡萄是近年来海南的新型产业,发展潜力巨大。2023年2月8日,原国家基金委罗晶处长一行赴欧乐影院
热带果蔬保鲜技术团队的芒果基地、火龙果基地和葡萄种植基地进行调研。该基地位于海南省陵水县英州镇,属于科技型龙头企业——景乾果业有限公司,结果考察调研,罗处长就海南芒果产业、火龙果产业和葡萄产业发展、采后处理技术、物流运输等各方面提出了建设性的指导意见。

图34. 芒果基地及采后处理加工厂调研现场
图35. 火龙果种植基地和葡萄种植基地调研现场
编辑:史程风 审核人:韩晓燕
签发人:杨小锋